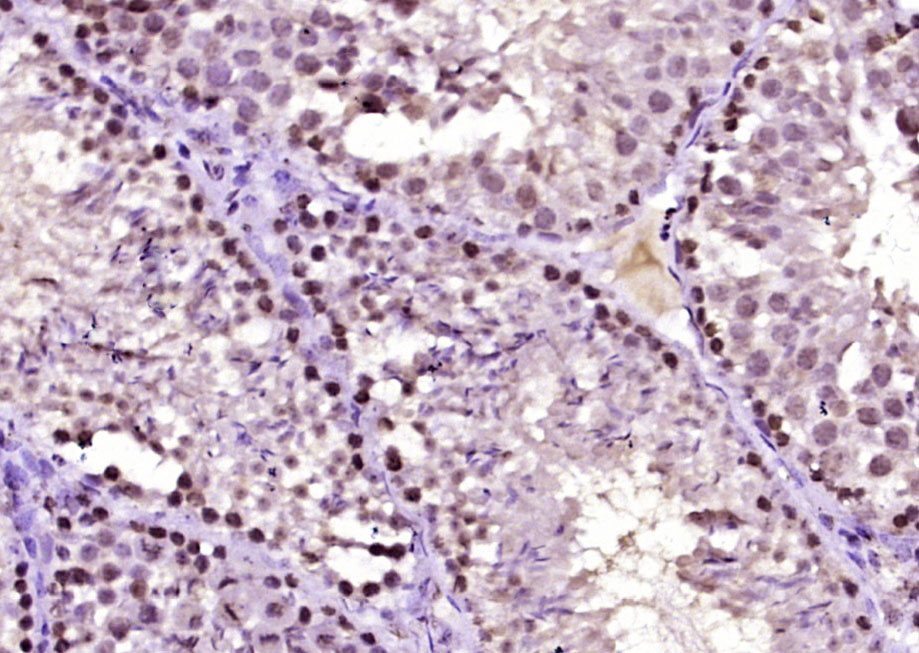
Paraformaldehyde-fixed, paraffin embedded Mouse testis; Antigen retrieval by boiling in sodium citrate buffer (pH6.0) for 15min; Block endogenous peroxidase by 3% hydrogen peroxide for 20 minutes; Blocking buffer (normal goat serum) at 37°C for 30min; Antibody incubation with HSP40 homolog Polyclonal Antibody, Unconjugated (bs-6002R) at 1:400 overnight at 4°C, DAB staining.

Immunohistochemical staining of human thyroid gland shows strong cytoplasmic positivity in glandular cells.
Anti-DNAJB4 Antibody
HPA028383
ApplicationsWestern Blot, ImmunoCytoChemistry, ImmunoHistoChemistry
Product group Antibodies
ReactivityHuman
TargetDNAJB4
Overview
- SupplierAtlas Antibodies
- Product NameAnti-DNAJB4 Antibody
- Delivery Days Customer4
- ApplicationsWestern Blot, ImmunoCytoChemistry, ImmunoHistoChemistry
- CertificationResearch Use Only
- ClonalityPolyclonal
- ConjugateUnconjugated
- Gene ID11080
- Target nameDNAJB4
- Target descriptionDnaJ heat shock protein family (Hsp40) member B4
- Target synonymsCMYO21, CMYP21, DNAJW, DjB4, HLJ1, dnaJ homolog subfamily B member 4, DnaJ (Hsp40) homolog, subfamily B, member 4, DnaJ-like heat shock protein 40, HSP40 homolog, heat shock 40 kDa protein 1 homolog, heat shock protein 40 homolog, human liver DnaJ-like protein
- HostRabbit
- IsotypeIgG
- Protein IDQ9UDY4
- Protein NameDnaJ homolog subfamily B member 4
- Scientific DescriptionRecombinant Protein Epitope Signature Tag (PrEST) antigen sequence
- ReactivityHuman
- Storage Instruction-20°C,2°C to 8°C
- UNSPSC41116161